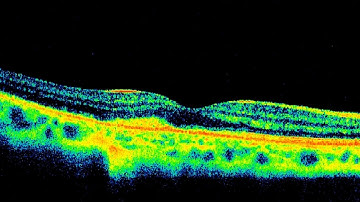
Choroidal Neovascularization

⬇ DOWNLOAD NOW
Kalau muncul iklan pop-up, tutup lalu klik tombol kembali
Download lagu Choroidal Neovascularisation-Accidental finding secara gratis hanya untuk keperluan promosi. Dukung artis favorit kamu dengan membeli musik original di iTunes atau platform resmi lainnya.
![Choroidal neovascularization after intraocular foreign body - Video abstract [62312]](https://i.ytimg.com/vi/apKwB_7i-gM/hq720.jpg?sqp=-oaymwEpCOgCEMoBSFryq4qpAxsIARUAAAAAGAElAADIQj0AgKJDeAHtAWZm5kE=&rs=AOn4CLDWVRahWr42hopGbGJ6jCrYpydD3w) Choroidal neovascularization after intraocular foreign body - Video abstract [62312]
Choroidal neovascularization after intraocular foreign body - Video abstract [62312]
 The Development of Chroidal Neovascularization (CNV)
The Development of Chroidal Neovascularization (CNV)
 Choroidal Neovascularization 2020
Choroidal Neovascularization 2020
Choroidal Neovascularization
Choroidal Neovascularization
 Choroidal Neovascularization (CNV) vs. Diabetic Macular Edema (DME)
Choroidal Neovascularization (CNV) vs. Diabetic Macular Edema (DME)
 Causes of Choroidal Neovascularization. #maculardegeneration
Causes of Choroidal Neovascularization. #maculardegeneration
 Choroidal Neovascularization
Choroidal Neovascularization
 Myopic Choroidal Neovascularization (Myopic CNV) Explained
Myopic Choroidal Neovascularization (Myopic CNV) Explained